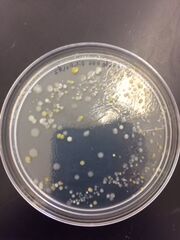

Uploads by Brooke Kazama
From OpenWetWare
Jump to navigationJump to search
This special page shows all uploaded files.
| Date | Name | Thumbnail | Size | Description |
|---|---|---|---|---|
| 16:07, 24 February 2016 | Foodweb 0471.JPG (file) |  |
21 KB | |
| 15:56, 21 February 2016 | Bug 0459.JPG (file) |  |
43 KB | |
| 15:56, 21 February 2016 | Bug 0458.JPG (file) |  |
29 KB | |
| 15:56, 21 February 2016 | Bug 0457.JPG (file) |  |
79 KB | |
| 15:56, 21 February 2016 | Bug 0456.JPG (file) |  |
202 KB | |
| 15:56, 21 February 2016 | Breadmold 0455.JPG (file) |  |
24 KB | |
| 03:07, 3 February 2016 | Nontetwhite 0442.JPG (file) |  |
16 KB | |
| 03:05, 3 February 2016 | Nontetyellow 0441.JPG (file) |  |
31 KB | |
| 02:54, 3 February 2016 | Tetyellow 0411.JPG (file) |  |
24 KB | |
| 02:54, 3 February 2016 | Tetwhite 0413.JPG (file) |  |
32 KB | |
| 02:54, 3 February 2016 | Tet 0407.JPG (file) |  |
31 KB | |
| 02:54, 3 February 2016 | Nontet 0406.JPG (file) | |
34 KB | |
| 15:55, 26 January 2016 | Dilution 0421.JPG (file) |  |
35 KB | |
| 15:53, 26 January 2016 | Protists 0420.JPG (file) |  |
21 KB | |
| 00:47, 19 January 2016 | Transect5 0373.JPG (file) |  |
1.91 MB | |
| 00:47, 19 January 2016 | Transect5 0372.JPG (file) |  |
1.51 MB | |
| 00:47, 19 January 2016 | Transect5 0371.JPG (file) |  |
1.63 MB | |
| 00:47, 19 January 2016 | Transect5 0370.JPG (file) |  |
1.46 MB | |
| 00:47, 19 January 2016 | Transect5 0369.JPG (file) |  |
1.7 MB | |
| 00:42, 19 January 2016 | Transect5 0368.JPG (file) |  |
1.73 MB | |
| 00:41, 19 January 2016 | Transect5 0367.JPG (file) |  |
1.86 MB | |
| 00:41, 19 January 2016 | Transect5 0366.JPG (file) |  |
1.54 MB | |
| 00:41, 19 January 2016 | Transect5 0365.JPG (file) |  |
1.64 MB | |
| 00:41, 19 January 2016 | Transect5 0364.JPG (file) |  |
1.54 MB | |
| 00:38, 19 January 2016 | Transect5 0363.JPG (file) |  |
1.6 MB | |
| 00:35, 19 January 2016 | Transect5.pdf (file) | 357 KB | ||
| 00:30, 19 January 2016 | Transect 5.pdf (file) | 357 KB |